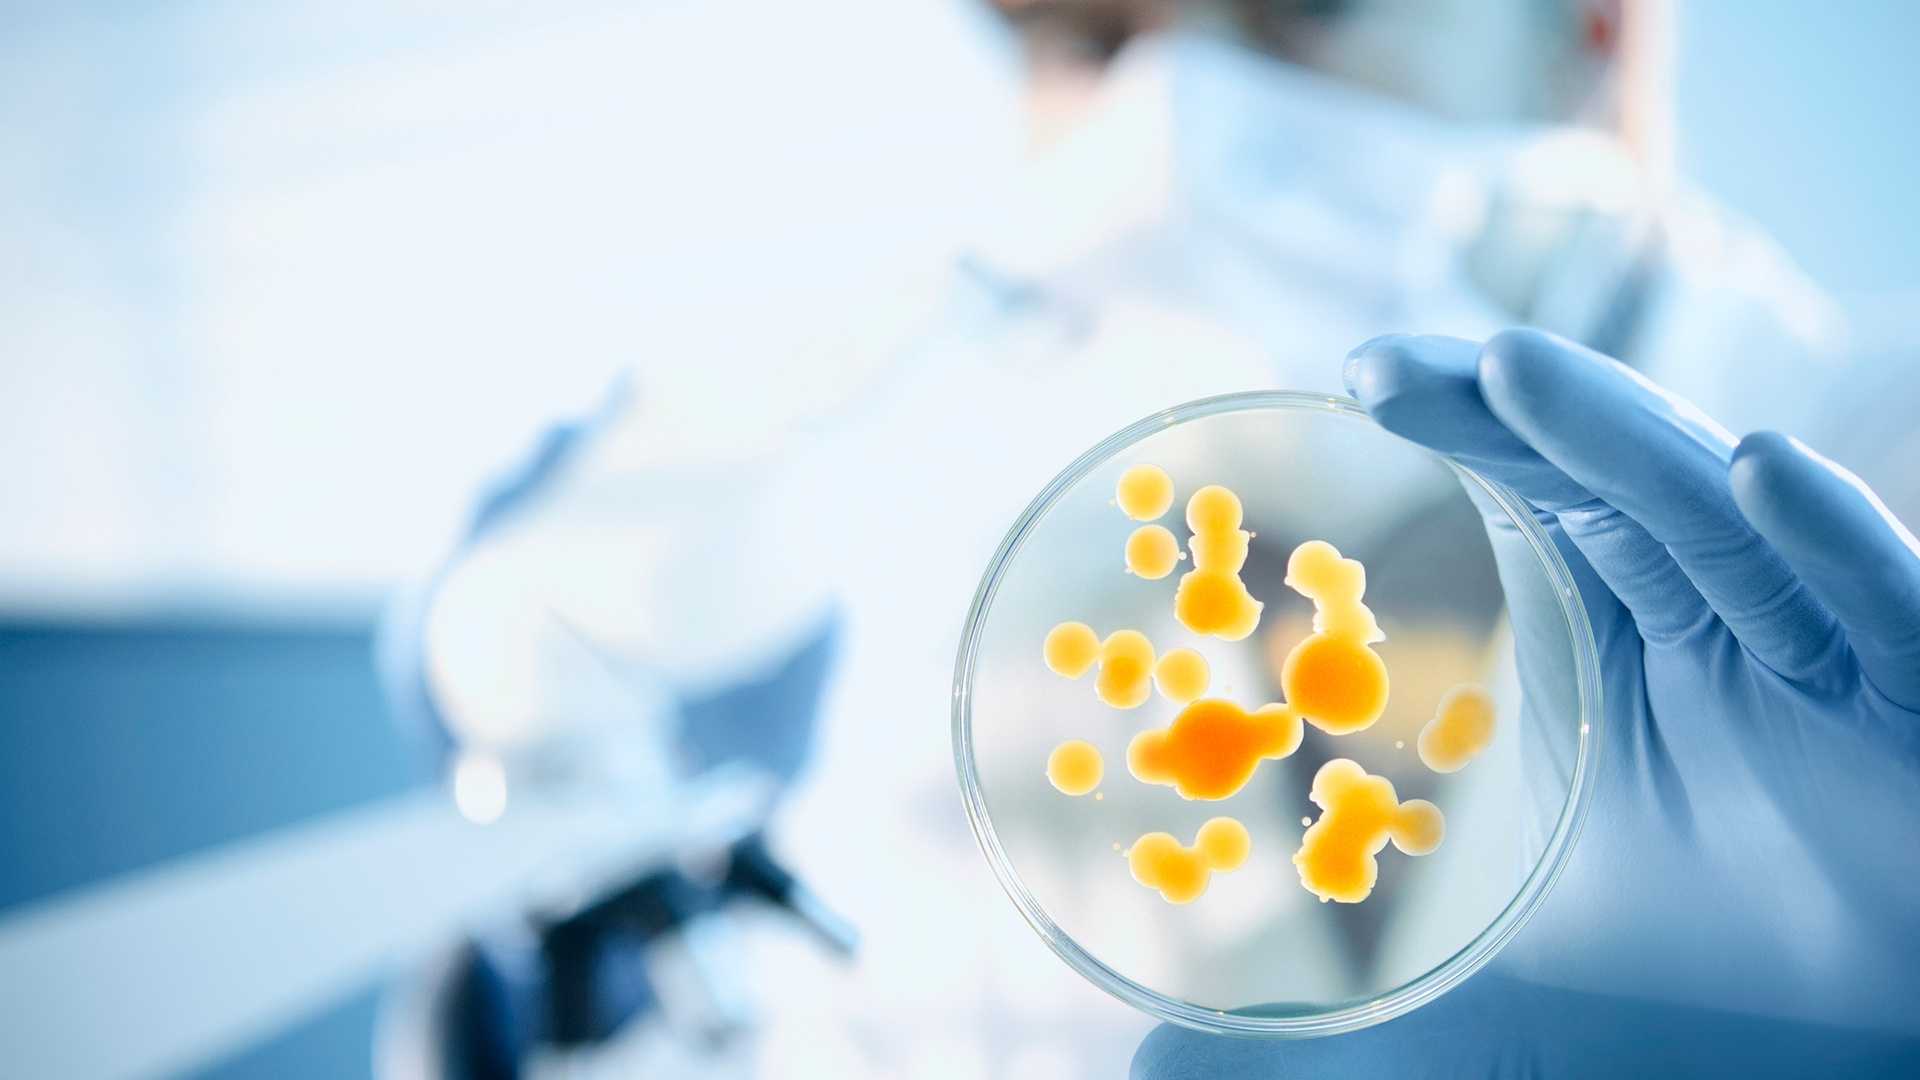

Standard Gas Mixtures for your application
In addition to pure gases, defined gas mixtures are required for routine applications in a variety of areas - from banana ripening to laser applications and the operation of ionization chambers. Thanks to their consistent composition, Messer can produce these as standard gas mixtures. Messer’s many years of experience and its employees’ high level of expertise in development, production and analysis ensure that we are always able to offer our customers the high quality standard they expect.
Individual gas mixtures
In order to meet the special requirements of our customers, Messer also produces individual gas mixtures. These custom gas mixtures are manufactured on demand. Typical examples are test and calibration gases for analytical instruments. Messer offers a variety of mixture categories (Tecline, Traceline, Labline and Topline) which define the tolerance, uncertainty and stability period.